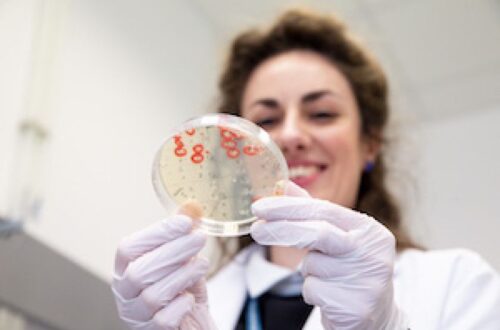

Viena didžiausių šalies statybos rinkos bendrovių „Conres “ praneša apie reikšmingą pokytį – tampa įmonių grupės dalimi. Lietuviško kapitalo įmonių grupė veikia „Conresta Group“ vardu.
Įkurtai įmonių grupei „Conresta Group“ vadovauja iki šiol „Conres“ direktoriaus pareigas ėjęs Lukas Laukaitis. Generalinės rangos įmonės „Conres“ vairą perėmė Ernestas Šeženis, iki šiol užėmęs direktoriaus pavaduotojo pareigas. Išskyrus pasikeitusį vadovą, pokyčių veikloje „Conres“ įmonė nenumato.
„Conres“ dalimi esu nuo pat įmonės įkūrimo, tad ne tik gerai jaučiu įmonės pulsą, bet ir išmanau svarbiausius veiklos principus. Vadovaudamas vienai didžiausių generalinės rangos įmonių šalyje sieksiu išlaikyti įmonės strateginę kryptį, esmines vertybes ir tęsiu pradėtus darbus“, – teigia E. Šeženis.
„Conresta Group“
Įmonių grupė vienija 6 įmones, iš kurių žinomiausios – generalinės rangos ir statybos paslaugas teikianti „Conres“ bei investicinio nekilnojamo turto plėtros sektoriuje veikianti „Recus“. Pastaroji įmonė Lietuvoje veiklą vykdo jau dešimtmetį. Be Lietuvos, „Conresta Group“ priklausančios įmonės šiuo metu veikia dar trijose šalyse: nuo 2017 m. vykdo veiklą Švedijoje, nuo 2018 m. – Karibuose esančioje Šv. Bartolomėjaus saloje, nuo 2021 m. – Prancūzijoje.
„Nors šalies verslas pastaraisiais metais gyveno neapibrėžtos rinkos sąlygomis, mūsų įmonėms pavyko ne tik išlaikyti stabilius rezultatus, bet ir reikšmingai paaugti. Per kelerius metus išsiplėtus veikloms skirtingose rinkose bei segmentuose – generalinės rangos, NT plėtros ir investavimo – nutarėme įkurti įmonių grupę“, – tikina sukurtos grupės vadovas L. Laukaitis.
Pokytį planavo kelerius metus
L. Laukaičio teigimu, įmonių grupės steigimas planuotas ir vykdytas nuosekliai, šis strateginis pokytis vyko kelerius metus.
„Plėtros žingsniai pradėti dėlioti dar iki įmonių grupės Lietuvoje įkūrimo 2020 metais. Šiandien, kai visi procesai galutinai išgryninti, turime visiškai funkcionuojančią įmonių grupę. Kalbant apie valdymo struktūrą, tam tikros paslaugos iš grupės visoms dukterinėms įmonėms bus teikiamos centralizuotai, esant poreikiui – prisidėsime prie grupės įmonių plėtros, konsultuosime strateginiais veiklos klausimais, o pati grupė dėmesį sutelkia į investicinę veiklą. Mums svarbu, kad šalyje rastųsi ilgalaikių ir tvarių projektų, kuriais galėtų didžiuotis ateities kartos, todėl tikėdami jų ilgaamžiškumu investuojame į jų plėtrą“, – pažymi L. Laukaitis.
Paklaustas, kaip verslo plėtros planus paveikė neapibrėžtas laikotarpis ir pastaraisiais metais įvykusi ne viena krizė, vadovas tikina, kad dėl šių aplinkybių įmonių grupės įkūrimo procesas tiesiog labiau išsitempė laike.
„Turėjome dėmesį paskirstyti spręsdami įvairius iššūkius, sąlygotus pandemijos, karo Ukrainoje, ekonomikos sulėtėjimo, medžiagų pabrangimo, aukštos infliacijos ir pan. Šios aplinkybės tikrai apsunkino verslo situaciją, tačiau visoms grupės įmonėms pavyko pademonstruoti atsparumą ir 2022 metais pasiekti virš 137 mln. eurų apyvartą. Džiaugiuosi, kad net ir permainingos rinkos sąlygomis mums pavyko ne tik stabiliai auginti finansinius rezultatus, bet ir įgyvendinti planuotą plėtrą bei tapti stipria įmonių grupe“, – teigia L. Laukaitis.
Vienija tie patys verslo principai
Anot pašnekovo, jau pats įmonių grupės pavadinimas rodo, kad ji išaugo iš vienos didžiausių šalies statybos sektoriaus žaidėjų „Conres“ (buvusios „Conresta“), kuri veiklą Lietuvoje vykdo nuo 2009-ųjų.
„Įmonių grupės pavadinimas pasirinktas neatsitiktinai: prieš metus statybos verslą vykdę „Conresta“ vardu, jį atnaujinome į „Conres“ – toks vardas geriau atliepė stabilų mūsų verslo augimą ir projektų tęstinumą užsienio rinkose. Jau tada žinojome, kad „Conresta Group“ prekės ženklas puikiai atspindės platesnę – visos mūsų įmonių grupės – veiklą. Mūsų vizija ir tikslai visiškai sutampa – atsakomybė ateičiai“, – pažymi L. Laukaitis.
Grupės vadovo teigimu, visas jų valdomas įmones vienija tos pačios stiprybės, padedančios sklandžiai įgyvendinti projektus: lankstus bendradarbiavimas, susitelkimas į tai, kas svarbu užsakovui, ir gebėjimas sumaniai savo veikloje taikyti šiuolaikinius technologinius sprendimus.
„Sujungdami savo kompanijas po vienu stogu dar stipriau užtvirtinsime savo pozicijas esamose rinkose ir sieksime pritraukti naujų partnerių. Tikime, kad bendrai sukaupta solidi patirtis leis pasiūlyti mūsų klientams kompleksinius ir profesionalius sprendimus“, – sako L. Laukaitis.
Pranešimą paskelbė: Lukas Laukaitis, UAB Conres LT